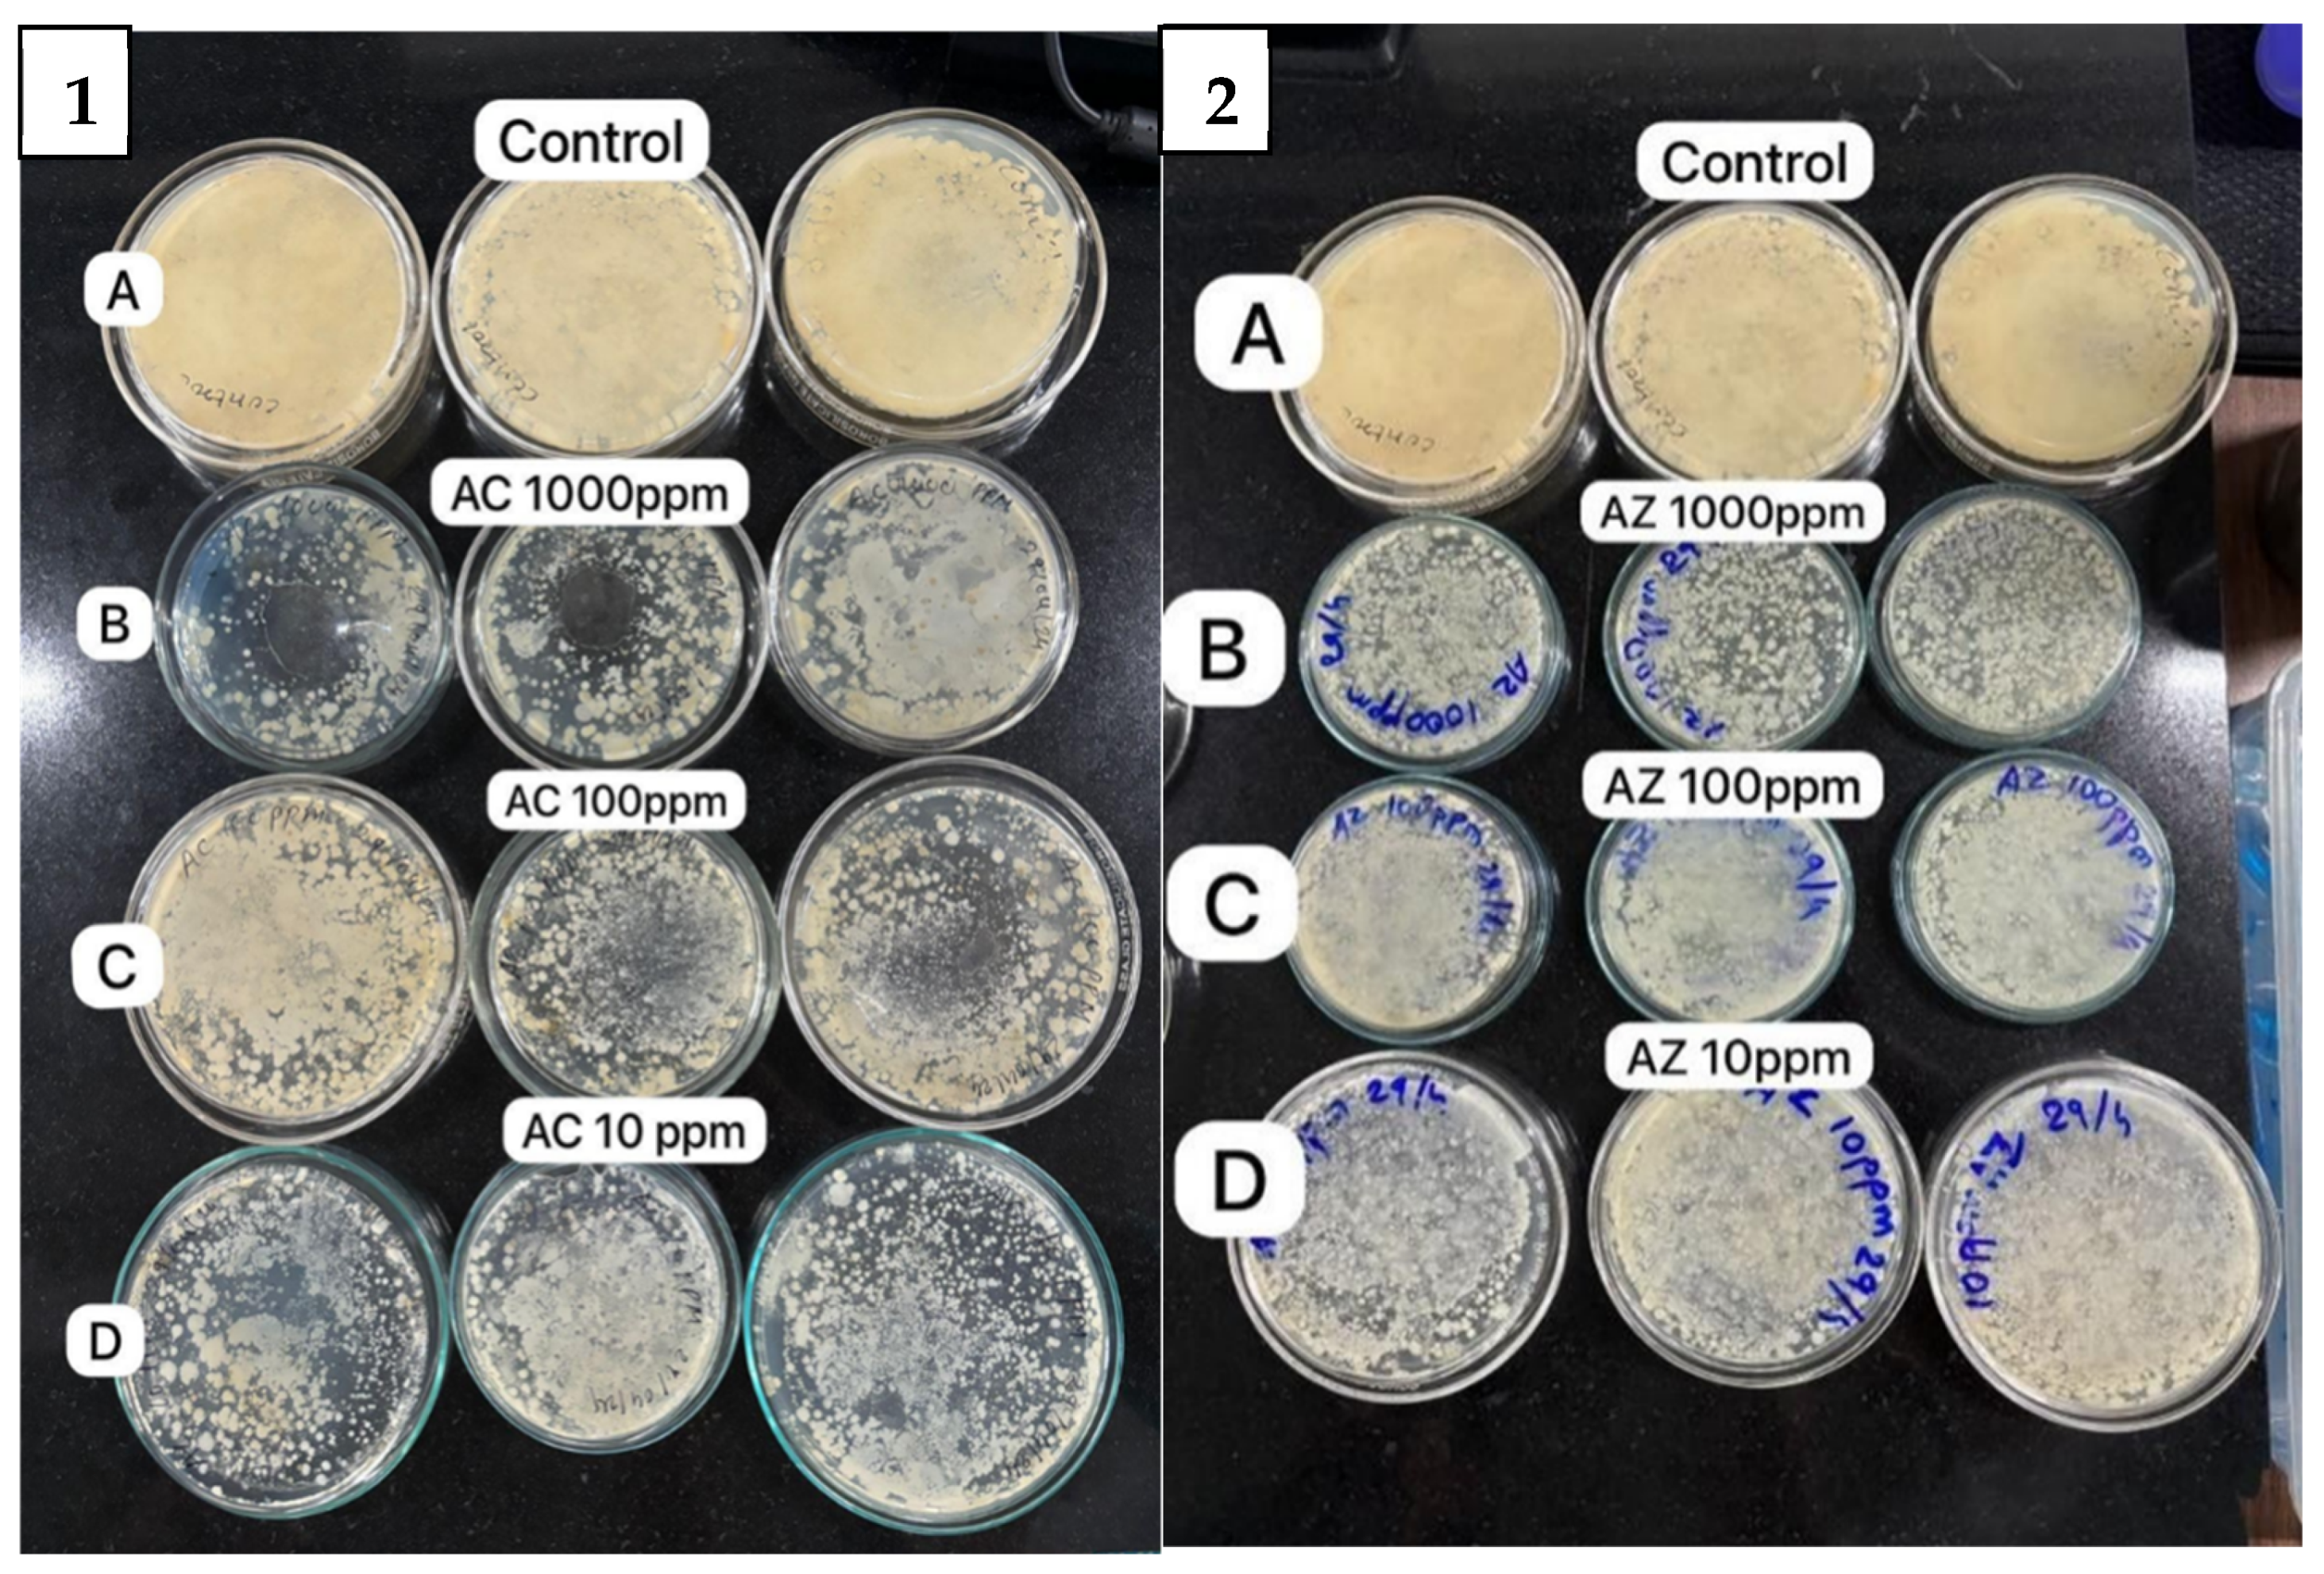
Bioengineering 11 01234 g010

Antibacterial Activity of Silver-Modified CuO Nanoparticle-Coated Masks
Abstract
1. Introduction
2. Materials and Methods
2.1. Synthesis and Deposition/Coating of Ag-CuO (AC) and Ag-ZnO (AZ) NPs on Masks
2.2. Characterization of Ag-CuO/ZnO
2.3. EPR Study
2.4. Antimicrobial Activity Test
2.4.1. Culturing Soil Bacteria
2.4.2. Culturing Air Bacteria
2.4.3. Agar-Plate Method
2.4.4. ZoI Method
3. Results
3.1. Morphology and Size of AC NPs Coated Disposable Surgical Masks
3.2. Structural Characterization of AC and AZ NPs Using XRD Analysis
3.3. Surface Functionality of Ag Modified CuO and Ag Modified ZnO NPs Using FT-IR Analysis
3.4. Evaluation of Antibacterial Activity
4. Summary and Conclusions
Supplementary Materials
Author Contributions
Funding
Institutional Review Board Statement
Informed Consent Statement
Data Availability Statement
Acknowledgments
Conflicts of Interest
Abbreviations
| Abbreviation | Full Form |
| AC | Ag-modified CuO Nanoparticles |
| AZ | Ag-modified ZuO Nanoparticles |
| ATR-FT-IR | Attenuated total reflectance–Fourior transform infrared spectroscopy |
| DMSO | Di methyl sulfoxide |
| DMPO | 5, 5-dimethyl-1-pyrroline N-oxide |
| EPR | Electro pramagnetic resonance |
| FE-SEM | Field emission–scanning electron microscopy |
| XRD | X-ray diffraction |
| ZoI | Zone of inhibition |
References
- Available online: https://www.nature.com/subjects/sars-cov-2 (accessed on 1 October 2024).
- Chung, Y.S.; Lee, N.J.; Woo, S.H.; Kim, J.M.; Kim, H.M.; Jo, H.J.; Park, Y.E.; Han, M.G. Validation of real-time RT-PCR for detection of SARS-CoV-2 in the early stages of the COVID-19 outbreak in the Republic of Korea. Sci. Rep. 2021, 11, 14817. [Google Scholar] [CrossRef] [PubMed]
- V’kovski, P.; Kratzel, A.; Steiner, S.; Stalder, H.; Thiel, V. Coronavirus biology and replication: Implications for SARS-CoV-2. Nat. Rev. Microbiol. 2021, 19, 155–170. [Google Scholar] [CrossRef] [PubMed]
- Salat, M.; Petkova, P.; Hoyo, J.; Perelshtein, I.; Gedanken, A.; Tzanov, T. Durable antimicrobial cotton textiles coated sonochemically with ZnO NPs embedded in an in-situ enzymatically generated bioadhesive. Carbohydr. Polym. 2018, 189, 198–203. [Google Scholar] [CrossRef] [PubMed]
- Nahum, Y.; Israeli, R.; Mircus, G.; Perelshtein, I.; Ehrenberg, M.; Gutfreund, S.; Gedanken, A.; Bahar, I. Antibacterial and physical properties of a novel sonochemical-assisted Zn-CuO contact lens nanocoating. Graefe’s Arch. Clin. Exp. Ophthalmol. 2019, 257, 95–100. [Google Scholar] [CrossRef]
- Ramirez, D.O.S.; Varesano, A.; Carletto, R.A.; Vineis, C.; Perelshtein, I.; Natan, M.; Perkas, N.; Banin, E.; Gedanken, A. Antibacterial properties of polypyrrole-treated fabrics by ultrasound deposition. Mater. Sci. Eng. C 2019, 102, 164–170. [Google Scholar] [CrossRef]
- Bertero, A.; Colombo, G.; Cortinovis, C.; Bassi, V.; Moschini, E.; Bellitto, N.; Perego, M.C.; Albonico, M.; Astori, E.; Dalle-Donne, I.; et al. In vitro copper oxide nanoparticle toxicity on intestinal barrier. J. Appl. Toxicol. 2021, 41, 291–302. [Google Scholar] [CrossRef]
- Fiandra, L.; Bonfanti, P.; Piunno, Y.; Nagvenkar, A.P.; Perlesthein, I.; Gedanken, A.; Saibene, M.; Colombo, A.; Mantecca, P. Hazard assessment of polymer-capped CuO and ZnO nanocolloids: A contribution to the safe-by-design implementation of biocidal agents. NanoImpact 2020, 17, 100195. [Google Scholar] [CrossRef]
- Ullah, H.; Zaman, W.; Ijaz, M.; Siyar, M.; Ullah, S.; Althomali, R.H.; Assiri, M.A.; Asif, S.U. Chemical assist rapid sonochemical synthesis of Cr doped SnO2 NPs for the hydrogen gas sensing application. Inorg. Chem. Commun. 2023, 157, 111351. [Google Scholar] [CrossRef]
- Ali Dheyab, M.; Aziz, A.A.; Jameel, M.S.; Khaniabadi, P.M.; Mehrdel, B. Sonochemical-assisted synthesis of highly stable gold NPs catalyst for decoloration of methylene blue dye. Inorg. Chem. Commun. 2021, 127, 108551. [Google Scholar] [CrossRef]
- Pathan, I.R.; Patel, M.K. A comprehensive review on the synthesis and applications of Schiff base ligand and metal complexes: A comparative study of conventional heating, microwave heating, and sonochemical methods. Inorg. Chem. Commun. 2023, 158, 111464. [Google Scholar] [CrossRef]
- Malka, E.; Perelshtein, I.; Lipovsky, A.; Shalom, Y.; Naparstek, L.; Perkas, N.; Patick, T.; Lubart, R.; Nitzan, Y.; Banin, E.; et al. Eradication of Multi-Drug Resistant Bacteria by a Novel Zn-doped CuO Nanocomposite. Small 2013, 9, 4069–4076. [Google Scholar] [CrossRef] [PubMed]
- Raposo, B.L.; Souza, S.O.; Santana, G.S.; Lima, M.T.A.; Sarmento-Neto, J.F.; Reboucas, J.S.; Pereira, G.; Santos, B.S.; Filho, P.E.C.; Ribeiro, M.S.; et al. A Novel Strategy Based on Zn(II) Porphyrins and Silver NPs to Photoinactivate Candida albicans. Int. J. Nanomed. 2023, 18, 3007–3020. [Google Scholar] [CrossRef] [PubMed]
- Menichetti, A.; Mavridi-Printezi, A.; Mordini, D.; Montalti, M. Effect of Size, Shape and Surface Functionalization on the Antibacterial Activity of Silver NPs. J. Funct. Biomater 2023, 14, 244. [Google Scholar] [CrossRef] [PubMed]
- Lipovsky, A.; Tzitrinovich, Z.; Friedmann, H.; Applerot, G.; Gedanken, A.; Lubart, R. EPR Study of Visible Light-Induced ROS Generation by NPs of ZnO. J. Phys. Chem. C 2009, 113, 15997–16001. [Google Scholar] [CrossRef]
- Lipovsky, A.; Nitzan, Y.; Gedanken, A.; Lubart, R. Antifungal activity of ZnO NPs—The role of ROS mediated cell injury. Nanotechnology 2011, 22, 105101. [Google Scholar] [CrossRef]
- Applerot, G.; Lellouche, J.; Lipovsky, A.; Nitzan, Y.; Lubart, R.; Gedanken, A.; Banin, E. Understanding the Antibacterial Mechanism of CuO NPs: Revealing the Route of Induced Oxidative Stress. Small 2012, 8, 3326–3337. [Google Scholar] [CrossRef]
- Mantecca, P.; Moschini, E.; Bonfanti, P.; Fascio, U.; Perelshtein, I.; Lipovsky, A.; Chirico, G.; Bacchetta, R.; Giacco, L.D.; Colombo, A.; et al. Toxicity Evaluation of a New Zn-Doped CuO Nanocomposite with Highly Effective Antibacterial Properties. Toxicol. Sci. 2015, 146, 16–30. [Google Scholar] [CrossRef]
- Archana, R.D.; Perelshtein, I.; Saibene, M.; Perkas, N.; Mantecca, P.; Nitzan, Y.; Gedanken, A. Antibacterial and In Vivo Studies of a Green, One-Pot Preparation of Copper/Zinc Oxide Nanoparticle-Coated Bandages. Membranes 2021, 11, 462. [Google Scholar] [CrossRef]
- Shankar, S.S.; Rai, A.; Ahmad, A.; Sastry, M. Rapid synthesis of Au, Ag, and bimetallic Au core–Ag shell NPs using Neem (Azadirachta indica) leaf broth. J. Colloid Interface Sci. 2004, 275, 496–502. [Google Scholar] [CrossRef]
- Méndez-Medrano, M.G.; Kowalska, E.; Lehoux, A.; Herissan, A.; Ohtani, B.; Bahena, D.; Briois, V.; Colbeau-Justin, C.; Rodríguez-López, J.L.; Remita, H. Surface Modification of TiO2 with Ag NPs and CuO Nanoclusters for Application in Photocatalysis. J. Phys. Chem. C 2016, 120, 5143–5154. [Google Scholar] [CrossRef]
- Preethi, D.R.A.; Philominal, A. Antimicrobial and antiurolithiatic activities of pure and silver doped copper oxide nanoparticles using Moringa Oleifera leaf extract on struvite urinary stones. Appl. Surf. Sci. Adv. 2022, 12, 100351. [Google Scholar] [CrossRef]
- Atacan, K.; Güy, N.; Ozmen, M.; Ozacar, M. Fabrication of silver doped different metal oxide nanoparticles and evaluation of their antibacterial and catalytic applications. App. Surf. Sci. Adv. 2021, 6, 100156. [Google Scholar] [CrossRef]
- Mantecca, P.; Kasemets, K.; Deokar, A.; Perelshtein, I.; Gedanken, A.; Bahk, Y.K.; Kianfar, B.; Wang, J. Airborne Nanoparticle Release and Toxicological Risk from Metal-Oxide-Coated Textiles: Toward a Multiscale Safe-by-Design Approach. Environ. Sci. Technol. 2017, 51, 9305–9317. [Google Scholar] [CrossRef] [PubMed]
- Perelshtein, I.; Ruderman, Y.; Perkas, N.; Beddow, J.; Singh, G.; Vinatoru, M.; Joyce, M.E.; Mason, T.J.; Blanes, M.; Molla, K.; et al. The sonochemical coating of cotton withstands 65 washing cycles at hospital washing standards and retains its antibacterial properties. Cellulose 2013, 20, 1215–1221. [Google Scholar] [CrossRef]

Disclaimer/Publisher’s Note: The statements, opinions and data contained in all publications are solely those of the individual author(s) and contributor(s) and not of MDPI and/or the editor(s). MDPI and/or the editor(s) disclaim responsibility for any injury to people or property resulting from any ideas, methods, instructions or products referred to in the content. |
© 2024 by the authors. Licensee MDPI, Basel, Switzerland. This article is an open access article distributed under the terms and conditions of the Creative Commons Attribution (CC BY) license (https://creativecommons.org/licenses/by/4.0/).
Share and Cite
Udawant, T.; Thorat, P.; Thapa, P.; Patel, M.; Shekhawat, S.; Patel, R.; Sudhir, A.; Hudka, O.; Pulidindi, I.N.; Deokar, A. Antibacterial Activity of Silver-Modified CuO Nanoparticle-Coated Masks. Bioengineering 2024, 11, 1234. https://doi.org/10.3390/bioengineering11121234
Udawant T, Thorat P, Thapa P, Patel M, Shekhawat S, Patel R, Sudhir A, Hudka O, Pulidindi IN, Deokar A. Antibacterial Activity of Silver-Modified CuO Nanoparticle-Coated Masks. Bioengineering. 2024; 11(12):1234. https://doi.org/10.3390/bioengineering11121234
Chicago/Turabian StyleUdawant, Tanuja, Prajkta Thorat, Payal Thapa, Manali Patel, Saroj Shekhawat, Roshni Patel, Ankit Sudhir, Om Hudka, Indra Neel Pulidindi, and Archana Deokar. 2024. "Antibacterial Activity of Silver-Modified CuO Nanoparticle-Coated Masks" Bioengineering 11, no. 12: 1234. https://doi.org/10.3390/bioengineering11121234
APA StyleUdawant, T., Thorat, P., Thapa, P., Patel, M., Shekhawat, S., Patel, R., Sudhir, A., Hudka, O., Pulidindi, I. N., & Deokar, A. (2024). Antibacterial Activity of Silver-Modified CuO Nanoparticle-Coated Masks. Bioengineering, 11(12), 1234. https://doi.org/10.3390/bioengineering11121234

